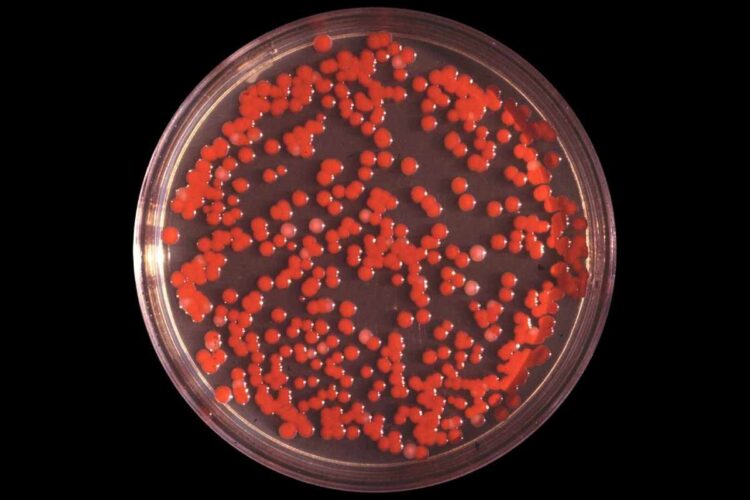
Colonie di Serratia dentro a una piastra Petri

La Serratia è un genere di batteri gram-negativi appartenente alla famiglia delle Enterobacteriaceae, presente in natura in molteplici ambienti. La specie più nota, la Serratia marcescens, si distingue per un pigmento rosso caratteristico ed è responsabile di numerose infezioni, soprattutto di tipo opportunistico e ospedaliero. Sebbene altre specie, come Serratia plymuthica o Serratia liquefaciens, possano causare patologie, sono molto meno comuni.
Serratia, dove si trova e come si contrae
Questo microrganismo ha un’ampia distribuzione: può essere individuato nel suolo, nelle acque superficiali e di scarico, su piante e animali, in particolare negli insetti, e persino nell’uomo. L’infezione si contrae per lo più in contesti ospedalieri, in seguito all’utilizzo di strumenti medici non sterilizzati, come cateteri o apparecchi per la ventilazione, ma anche attraverso trasfusioni o infusioni contaminate. Procedure invasive, ricoveri prolungati e scarsa igiene delle mani e delle attrezzature aumentano notevolmente il rischio di contagio.
I fattori di rischio
Le persone con un sistema immunitario compromesso sono particolarmente vulnerabili, così come chi segue terapie a base di corticosteroidi o chemioterapici, i neonati prematuri o con basso peso alla nascita e i pazienti sottoposti a interventi chirurgici. Anche anziani e soggetti che hanno subito traumi importanti presentano una prognosi più delicata in caso di infezione.
Malattie e sintomi delle infezioni da Serratia
Le infezioni da Serratia marcescens possono colpire diversi distretti dell’organismo. Tra le patologie più frequenti figurano infezioni delle vie urinarie, respiratorie e gastrointestinali, oltre a forme cutanee, intra-addominali, oculari e post-chirurgiche. In casi più gravi possono insorgere meningiti, endocarditi, osteomieliti, artriti settiche, otiti e parotiti. Non mancano episodi di infezioni ematiche che, nei quadri più severi, evolvono in sepsi.
I sintomi variano in base alla sede colpita ma spesso comprendono febbre, brividi, tachicardia, difficoltà respiratorie e, nei casi estremi, shock settico.
Diagnosi e trattamento
La diagnosi non può basarsi solo sui sintomi: è necessario eseguire analisi di laboratorio e isolare il batterio tramite coltura di campioni clinici prelevati da sangue, urina o secrezioni respiratorie. Questo passaggio consente di identificare con precisione la presenza della Serratia e di stabilire la terapia più adeguata.
Il trattamento si fonda sull’uso di antibiotici, ma non esiste un farmaco unico di riferimento, poiché il batterio mostra resistenze intrinseche e acquisite. La scelta del medicinale dipende dalla localizzazione dell’infezione, dalla capacità del farmaco di raggiungere i tessuti interessati e dai risultati dei test di sensibilità. La durata della terapia varia in base alla gravità e all’estensione della malattia.
Prognosi e prevenzione
La probabilità di guarigione è legata allo stato di salute generale del paziente, alla rapidità della diagnosi e alla resistenza del batterio agli antibiotici. Nei bambini piccoli, negli immunodepressi e negli anziani l’infezione tende a essere più aggressiva, richiedendo un monitoraggio costante e cure tempestive. La prevenzione passa da un’attenta igiene delle mani, una corretta disinfezione delle attrezzature mediche e il rispetto rigoroso dei protocolli ospedalieri.